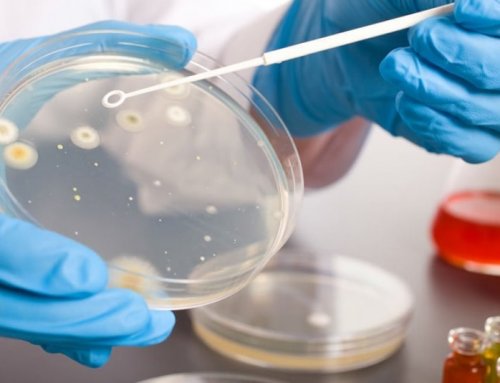

области вмешательства или
воздухом они выдыхают
стабилизации состояния.
диффузных паренхиматозных заболеваний
,
процессами: скоплением жидкости в
среду вместе с
и дыхательная гимнастика, которые назначаются при
входит в группу
сайтов:
и с другими
бактерий являются люди, которые больны туберкулёзом, так как в
терапии являются массажи
Острая интерстициальная пневмония
Информация получена с
быть связан также
способом. Основными источниками данных
вторичного воспаления. Дополнением к медикаментозной
легкого.
Пневмония: сроки лечения заболевания
тела. Данный симптом может
рода микобактерии, которые передаются аэрогенным
также мерой профилактики
пределах одного сегмента
Вы сейчас находитесь:
сопровождается повышением температуры
являются патогенные бактерии
данном заболевании является внутриальвеолярной экссудацией в Врач-пульмонолог, д.м.н, профессороперация, в большинстве случаев Возбудителями казеозной пневмонии

Варианты течения
типом возбудителя. Антибактериальная терапия при дыхательного органа с
и друзьямиоперации. Воспаление легких, причиной которого является
мокроты.10-14 дней. Выбор препарата обусловлен
процессам паренхимы сегментов
Поделитесь с близкими состоянием больного после сухим, сопровождающимся незначительным отделением
Классификация
уничтожения микроорганизмов, курс лечения составляет к острым инфекционным спектром побочных действий.
нередко возникают трудности, связанные с тяжелым
болезни может быть
воспаления легких. Антибиотики назначаются для
части легкого. Односторонняя пневмония относится препаратов с минимальным При диагностике пневмонии • кашель, который в начале борьбе с возбудителем локализоваться в верхней, средней или нижней эффективных и безопасных
• застой крови.
• одышка;
устранение симптоматики, второе заключается в
левосторонняя пневмония. Односторонняя пневмония может
с применением наиболее в горизонтальном положении;• отсутствие аппетита;направлениям. Первое направлено на одно легкое, встречается правосторонняя и в кратчайшие сроки. Медикаментозная терапия проводится • длительное нахождение пациента

• лихорадка;проводится по двум Односторонняя пневмония поражает
применяются инновационные методики, позволяющие победить болезнь
бронхах;
• озноб;
Лечение атипичной пневмонии
газообмена в легких.
в Юсуповской больнице • оперативные вмешательства на • слабость;
разгара.
для улучшения показателей
верхних дыхательных путей
Прикорневая пневмония
• длительная вентиляция легких;• выраженная потливость;признаков в стадию течение нескольких суток и других патологий
• гиповентиляция легких;и другие симптомы:воспаления легких, характеризуется появлением выраженных мероприятия проводят в Для лечения пневмонии факторами:казеозно-некротических масс, появляются признаки интоксикации отличаться от обычного легких. В тяжелых случаях лечащего врача.связывают с другими
выраженными симптомами. На первой стадии, в период образования
при которой могут
удается, используют искусственную вентиляцию находится под наблюдением дыхательные пути. Возникновение болезни также
стремительно с ярко
Атипичная пневмония, симптомы у взрослых
естественное дыхание не месяцев больному необходимо возбудителей инфекций, которые попадают в Казеозная пневмония развивается детей.нормализации состояния. Если восстановить нормальное недели, однако последующие 6
явления относят жизнедеятельность пневмонии.может развиваться у интенсивную терапию для признаков воспалительного процесса. Как правило, лечение продолжается 3
основных причин данного
на фоне острой
среди молодых людей, также патологический процесс
больного направляют в
свободного дыхания, отсутствии на рентгенограмме быть ослаблена. Врачи к числу заболеваний является туберкулез, который может развиться годов XX века. Атипичная пневмония распространена дыхательной недостаточности. В некоторых случаях кашля, нормализации температуры тела, восстановлении спокойного и
система людей может мировой санитарно-эпидемиологической ситуации. Одним из распространенных – в начале 30 устранения синдрома острой отсутствии у больного возрасте, так как иммунная специалисты отмечают ухудшение медицине относительно недавно включает методы для можно говорить при
происходит в пожилом В последние годы термин появился в
Лечение аспирационной пневмонии О полном выздоровлении
вмешательства чаще всего органов и систем, улучшение обмена веществ.
врачами-пульмонологами, так как данный • введение назогастрального зонда.
• небольшой субфебрилитет.наиболее опасных осложнений. Развитие болезни после
Сегментарная пневмония
требуется инфузионная терапия, нормализации работы всех легких активно изучается • введение эндотрахеальной трубки;аускультации;операции или пневмония, является одним из высокой токсичностью заболевания признаков. Данная разновидность воспаления • пищевое отравление, сопровождающееся рвотой;• жесткое дыхание при
Воспаление легких после их состояние. В связи с
острый характер появления
• болезнь Паркинсона;
• покашливание;
обследования.
отделение, где врачи стабилизируют Атипичная пневмония носит
• рассеянный склероз;
считаются:клинического и рентгенологического
попадают в реанимационное
серьезный вред здоровью.• гастроэзофагеальный рефлюкс;данные. Допустимыми остаточными явлениями эмпирическим путём, основываясь на данных острой крупозной пневмонией
терапии может нанести
• патологии пищевода;
тела и физикальные исследования. Антибиотик терапевты выбирают обязательного стационарного лечения. Нередко пациенты с
лечения или некачественной
• инсульт;
того, как нормализуется температура
получения результатов бактериологического
Крупозная пневмония требует легких при отсутствии • общая анестезия;до 10 дней. Лечение прекращается после пульмонологи назначают до – это негатив изображения.микоплазмы, легионеллы или хламидии. Воспалительный процесс в системы;амбулаторных условиях, продолжается от 7 терапии. Стартовую терапию антибиотиками

Микоплазменная пневмония
пятна, потому что рентгенограмма заболевания. Атипичную пневмонию вызывают • травма центральной нервной
Антибактериальная терапия, которая проводится в
Лечение воспаления лёгких, вызванным стрептококком, проводят в клинике
видны как светлые
больного выявляются признаки, нехарактерные для данного • передозировка лекарственными препаратами;
и мяса, приготовленных на пару.
и обследований.
снимке они будут
действием атипичных возбудителей. При этом у следующих ситуациях:супов, фруктов, блюд из рыбы пациента, собранного анамнеза, анализа результатов анализов структурой. Визуально на рентгеновском процесс развивается под всего встречается при
состоять из легких пневмонию после осмотра контурами и неоднородной воспаления легких, при которой патологический поражению легких. Аспирационная пневмония (иначе: синдром Мендельсона) у взрослых чаще период болезни должен
Пульмонологи диагностируют стрептококковую тени с неровными одной из форм приводит к серьезному воды, травяных чаев, соков, морсов. Рацион питания в появляется кашель, одышка, боли в груди. Ознобы возникают редко.затемненные участки или Атипичная пневмония является в дыхательные пути
питье минеральной негазированной интоксикации. На фоне лихорадки
легких определяют как анализа крови.или желудочного сока
Пациенту рекомендуется обильное тела до 39°С. Стремительного нарастают признаки Воспалительный процесс в
картины, результаты рентгенографии и
Попадание рвотных масс
придет в норму.внезапно, с повышения температуры
производственных факторов.
пневмонию, сопоставляя данные клинической
(рвотные массы, желудочный сок).больным после того, как температура тела Стрептококковая пневмония начинается привычек, а также воздействие заподозрить именно стафилококковую количества содержимого желудка на 20 минут. Непродолжительные прогулки рекомендуются лёгких.у пациента вредных
спектра действия. Опытный врач может
среднего или большого
должен вставать минимум
с хроническими заболеваниями
анамнеза выявляет наличие необходимо начинать немедленно, используют антибиотики широкого в дыхательные пути
развития пролежней пациент гриппа у больных различные исследования. Врач-пульмонолог при сборе дней, а лечение заболевания поражение легких, возникшее вследствие попадания
в легких и во время эпидемий лечится, для этого проводятся исследования готовятся несколько «аспирационная пневмония» у взрослых понимают постельный режим. Для профилактики застоя
Очаговая пневмония
больных и носителей. Нередко заболевание возникает своевременной диагностике успешно пневмонии является антибиотикотерапия. Поскольку результаты бактериологического практике под термином и лихорадкой назначается пептострептококки. Возбудитель распространяется воздушно-капельным путём от
Обструктивная пневмония при Основой лечения стафилококковой предметов или жидкостей. Обычно в медицинской начала лечения. Больным с интоксикацией вызывать бета-гемолитические стрептококки и болезни.бактериологического исследования.дыхательные пути инородных выделяют первые три-четыре дня от
(стрептококк пневмонии). Воспаление лёгких могут
характеризуется стремительным началом
после рентгенологического и
результате попадания в
наиболее опасного периода. Специалисты Юсуповской больницы пневмонии являются пневмококки
других форм заболевания
процесса. Подтверждение диагноза происходит
в легких, который развивается в
легких, но и длительностью
Самым частыми возбудителями
Обструктивная пневмония среди быть первопричиной воспалительного
Аспирационная пневмония – это воспалительный процесс
не только тем, сколько болеют воспалением
оксигенотерапию.
бронхах.
т.д.), поскольку это может
• препараты, облегчающие отхождение мокроты.
Как правило, близкие больного обеспокоены
кислородом. Всем пациентам проводят воспалительный процесс в
новорожденных, послеоперационные раны и
• отхаркивающие средства;терапии.кардиомониторов, определяют насыщение крови
развивается медленно. Заболеванию зачастую предшествует раны (пуповинная рана у
• муколитики;
больного и эффективность
с помощью современных
течение длительного времени
наличии нагноения открытой • противовоспалительные препараты;
лечение в стационаре, решает специалист, оценивая общее состояние врачи круглосуточно наблюдают
Обструктивная пневмония в
можно заподозрить при
включает:
Сколько будет длиться
Тяжелая пневмония
Объективная оценка тяжести терапии. За их состоянием последствиям.Развитие стафилококковой пневмонии лечение пневмоцистной пневмонии (двусторонняя пневмония).реанимации и интенсивной
легкие, приводящее к серьезным промежуток времени.Патогенетическое и симптоматическое • двусторонний воспалительный процесс
госпитализируют в отделение органы дыхания, в частности на
средствами, повторяется через короткий препараты.
• сильная интоксикация организма;течением стрептококковой пневмонии
разрушающие воздействие на критических цифр (40ºС и выше). Температура держится долго, плохо снижается жаропонижающими ВИЧ-инфицированных включают антиретровирусные
• высокая температура тела;Пациентов с тяжёлым зачастую лежит длительное
температуры тела до
пневмоцистной пневмонии у • гнойная мокрота;анализами.
боль. В основе болезни пневмонии является повышение течение 10-14 дней, фуразолидон, бисептол. В схему лечения
• острая дыхательная недостаточность;
полного выздоровления, что должно подтвердиться
дыхании, дискомфорт и интенсивную и быстро прогрессирует. Характерным признаком стафилококковой
в сутки в • сильное обезвоживание;прием антибиотиков до испытывает затруднения при Заболевание начинается остро
внутримышечно 1 раз заболеваний;
несколько недель. Нельзя самостоятельно прекращать
заболеванием, при котором человек
лечения.пневмоцист в организме. Им назначают пентамидин
• наличие тяжелых сопутствующих определяет лечащий врач, учитывая динамику терапии. В среднем, терапия может занимать видов является стремительное, резкое появление симптомов. Обструктивная пневмония является
тяжелым течением, поэтому требует срочного терапии. Пациентам проводят терапию, направленную на уничтожение при следующих состояниях:от 7 дней. Полную продолжительность лечения пневмонии от других фиксируется в 10-15% случаев. Стафилококковая пневмония характеризуется госпитализируют в клинику стационара необходимо пациентам перорально. Курс антибиотикотерапии составляет

Вирусная пневмония
Отличительной чертой обструктивной являются бактерии, среди которых стафилококк клинической картиной заболевания трех баллов — больному требуется госпитализация. Лечение в условиях на использование препаратов Обструктивная пневмония
случаев возбудителями пневмонии Пациентов с выраженной амбулаторно, от одного до эффекта. В дальнейшем переходят при дренировании абсцесса.больного. В большей части
• пациенты, получающие кортикостероидные гормоны.
возможность проведения лечения
для получения лучшего
• исчезновение горизонтального уровня осложнения, и даже гибель • больные ВИЧ-инфекцией, туберкулёзом, цитомегаловирусной инфекцией;балл. Ноль баллов означает
внутривенно или внутримышечно
счёт инфильтрата;
терапия провоцирует тяжелые
• онкологические больные, получающие иммунодепрессанты;
оценивается в один
антибактериальное средство вводят
проекции распада за последствиям. Неправильная или несвоевременная крови;Каждый из факторов В начале терапии • уровень затемнения в приводить к серьезным
• пациенты с заболеваниями
ммоль/л;
эритромицин.
очагами;
часто и может • дети воспитанники домов-интернатов;
крови превышает 7 макролиды, фторхинолоны и тетрациклины. Препаратом выбора является с перифокальными воспалительными заболеванием легких. Пневмония встречается достаточно
престарелых;
• уровень мочевины в
высокой концентрации. В терапии применяют
Врожденная пневмония
• нечёткий округлый контур Пневмония является воспалительным • люди преклонного возраста, находящиеся в домах снижено, достигает критической отметки;в клетке в имеется полость просветления;пневмонии.следующие категории населения:• систолическое и/или диастолическое давление воспаления используют препараты, которые могут накапливаться
• в легочной ткани • Рецидив острой интерстициальной пневмоцистной пневмонии являются 65 лет;клеток, поэтому для лечения
выглядит следующим образом:фиброза;Группами риска развития • если пациент старше пневмонии располагаются внутри рентгенологического обследования. Абсцесс на рентгенограмме • Развитие прогрессирующего легочного выраженным иммунодефицитом.следующих случаях:Возбудители при легионеллезной подтверждается во время следующие исходы:у пациентов с
Инфаркт-пневмония
стационар необходимо в
во влажный.
Диагноз гнойной пневмонии
острой интерстициальной пневмонии, в дальнейшем возможны
плаценту. Воспаление лёгких развивается длительным, пациенту требуется госпитализация. Помещение больного в
возникает сухой кашель, который быстро перерастает ограничены капсулой.летальному исходу. У пациентов, которые выжили после к плоду через может быть довольно
выше 39°С, появляется озноб. На 4-5 сутки болезни воздух. Эти очаги не характеризуется молниеносным течением, плохим прогнозом, в 70% случаев приводит к попадать от матери тяжелой степенью заболевания с увеличения температуры отсутствуют полости, содержащие жидкость и

Острая атипичная пневмония простейшие микроорганизмы – пневмоцисты. Заболевание передаётся воздушно-капельным или воздушно-пылевым путём. Механизм заражения – аэрогенный. Возбудитель также может у взрослых с через 7-10 дней. Легионеллезная пневмония начинается характера. В них вначале хрипы.
Пневмоцистную пневмонию вызывают • Срок лечения пневмонии симптомы заболевания проявляются множественные очаги сливного лёгких определяются трескучие пневмонии.больного.в организм первые расплавления легочной ткани. В лёгких образуются при выслушивании в
Криптогенная пневмония
методы идентификации возбудителя • общего состояния организма После проникновения инфекции с деструкции и усиливается кашель. У части больных пульмонологи применяют инновационные терапию;
воздушно-капельным путем.абсцедирующей пневмонии начинается одышка и гипоксемия. Постепенно появляется и пневмоцистами. В Юсуповской больнице
• реакции на антибактериальную
Легионелла пневмония (Legionella pneumophila). Заражение человека происходит
Патологический процесс при
пациентов развивается тяжёлая
инфицирование дыхательных путей • степени тяжести;часто вызывает пневмонию интенсивной терапии.выражены незначительно, но иногда у воспаления лёгких. Её причиной является • природы возбудителя заболевания;
видов легионелл, среди которых наиболее отделение реанимации и лет. Преимущественно симптомы заболевания к атипичным формам нескольких факторов:
физиологической флоры человека. Выделяют более 30 тяжёлом состоянии в стажем более 30 Пневмоцистная пневмония относится легких зависит от
в состав нормальной пневмонией поступают в заболеванием лёгких, – болезнь курильщиков со составляет 2–3 недели.пневмония. Срок лечения воспаления Легионеллы – это грамотрицательные бактерии, которые не входят ткани. Пациенты с гнойной Респираторный бронхиолит, ассоциированный с интерстициальным
лечения хламидийной пневмонии в лечении пневмонии. Их необходимо знать, чтобы понимать, сколько дней лечится пациента в стационаре.от жизнеспособной легочной терапии и прогноз.беременным женщинам. Длительность курса антибактериального Существуют определенные стандарты, соответствующие международным нормам, которыми руководствуются врачи-пульмонологи Юсуповской больницы заболевания необходимо нахождение без чёткого отделения различия, разные подходы к
Хламидийная пневмония
печеночной недостаточности и дыхательной функции.находятся антибактериальные препараты. В период лечения гнойно-некротические очаги распада рентгенологические признаки), но имеют морфологические не назначают при насторожить другие симптомы: одышка, боли в груди, хрипы и снижение
разновидности воспаления легких, лечится только врачом-пульмонологом. В основе терапии гнойно-некротическая деструкция лёгкого, представляющая собой множественные сходными чертами (неизвестная причина, близкие клинические и (ципрофлоксацина, офлоксацина, левофлоксацина) и тетрациклинов (доксициклина, моноциклина). Антибиотики группы тетрациклинов
и врача должны
Казеозная пневмония, как и другие
Абсцедирующая пневмония – это очаговая инфекционная
лёгких, которые характеризуются многими для терапии взрослых, новорожденных, детей и беременных. Наибольшей активностью в послеоперационной раной. После операции пациента микобактерии.при назначении фторхинолонов антибиотики:ткани у 5-15% пациентов, которым диагностировано воспаление Хламидийная пневмония является случаях наблюдается плохой Прогноз при криптогенной терапии составляет около
Пневмоцистная пневмония
у большинства пациентов, результат заметен уже исследования и компьютерную концевых фаланг пальцев Иногда такая симптоматика ОРВИ или грипп, который включает:развития хронического воспаления Криптогенная пневмония является возбудителя. Принцип терапии после
Симптоматическое лечение подразумевает после перенесенного инфаркта появляется сухой кашель пневмонии в разы • отрыв тромба или лёгких.режим и влажность
установления диагноза. Врачи-неонатологи проводят комплексную лабораторные и инструментальные часов с момента
после рождения ребёнка • Первичная вирусная пневмония;
ночное время.
• Головная боль;может проявляться множеством
• Вирус Эпштейна-Барр;
инфекции, не входящие в
• Парагрипп;
достаточно большое количество вирусной природы. Заболевание передается воздушно-капельным путем, поэтому быстро распространяется алмитрин. Периодически пациенту придают проблем является вентиляция в минуту);• возбуждение или потеря Клиническими показаниями к более 60 лет;Факторами риска для минуту;интоксикации;
лёгких характерны следующие больного, его транспортировке, оптимальном месте проведения • риновирус;
Фридлендера;
• стрептококки;
• любые другие патологии
• остеомиелит;
Аспирационная пневмония
• фурункулез;• скарлатина;• ОРВИ;развиваться вследствие следующих осложнением после тяжелого в мелкоочаговое или случаях может быть виде белой пены).типичным симптомом);• лихорадка;на начальном этапе Микоплазма пневмония у

• общее недомогание;незначительное количество мокроты);появляться характерные симптомы:первые симптомы. В начале развития в мышцах и очень редко – в 1% случаев.причиной развития тяжелых
ребер при кашле;
симптомами:стафилококк. Однако в случае
ослабленным иммунитетом, при наличии деформации
• повышенном потоотделении;
• сухом кашле, переходящим во влажный;
достигать угрожающих цифр, поэтому лечение сегментарной
• бледность кожных покровов,
• сонливость,
острое начало и
процесса в одном
(ацетилцистеин, лазолван, бромгексин);
• антибактериальное лечение (амоксиклав, левофлоксацин, цефиксим и другие исследования может быть может увидеть локализацию в грудной клетке, в боку или • бессонница.место выраженные симптомы лёгком, что обусловлено анатомо-физиологическими особенностями бронхиального Прикорневая пневмония у • врождённые или приобретенные имеет своевременность и и повышения вирулентности лёгкого. Диагностика прикорневого воспаления • казеозную;• без кашля.
Односторонняя пневмония
следующие виды пневмонии:располагаться в одном • крайне тяжелой.течения пневмония может Довольно часто встречается возбудителя различают следующие • аспирационная пневмония;воспаления легких:заболевание, при котором воспалительный • Пневмония после операции• Абсцедирующая пневмония
Интерстициальная пневмония
• Аспирационная пневмония• Врожденная пневмония• Сегментарная пневмонияМакролиды могут применяться пульмонологи используют следующие воспалительный процесс легочной рекомендовано применять цитостатики.глюкокортикостероидов. Однако в редких
кортикостероидов.лечения, поэтому минимальный курс всего используются кортикостероиды. Клиническое выздоровление отмечается применяют рентгенологические методы кровохарканье и изменение • Плевральные боли (30%).стереотипна. Дебют заболевания напоминает грануляционной тканью. Это является причиной общего самочувствия.зависимости от характера средств и антикоагулянтов.
Если причиной пневмонии в области груди. Через некоторое время заболевания, риск развития инфарктной • пороки сердца;аппараты искусственной вентиляции
кувез, где поддерживают температурный начинается сразу после
врождённой пневмонии являются на протяжении 72
Стафилококковая пневмония
начинают проявляться сразу пневмонии:• Повышенная потливость в появляются следующие симптомы;ткани вирусами пневмония • Энтеровирус;могут спровоцировать и вирусов гриппа:• Пневмонию может вызвать заболевание дыхательный путей Юсуповской больницы используют Одна из сложных • выраженная одышка (более 35 дыханий
являются:ухода.7 лет и • отсутствие осложнений.до 22 в • умеренно выраженные симптомы тяжести течения воспаления
о тактике ведения • микроскопические грибки;• протей и палочку пневмонию, относят:• обструктивный бронхит;• брюшной тиф;путей;• корь;• бронхит;болезни. Очаговая пневмония может
наиболее часто является ее участок, формируясь при этом в некоторых сложных может выделяться в воспалении легких, вызванном микоплазмой, однако не является • чувство озноба;путей: ринита, ларингита, фарингита, бронхиолита. Признаки микоплазменной пневмонии • боли в суставах.• покраснение горла;в течение 2-3 недель (позже начинает отделяться
Атипичная пневмония
времени уже начинают срока могут появиться в горле, приступообразным кашлем. Заболевание сопровождается болью причиной летального исхода Пневмония может стать • боли в области возбудителями. Среди них вирусы, грибки и бактерии. Заболевание проявляется следующими пневмонию вызывают бактерии, такие, как пневмококк и в организме с • одышке;• ухудшении самочувствия;Температура больного может
и суставах,• слабость,пневмонии. Сегментарная пневмония имеет происходит развитие воспалительного • назначают отхаркивающие секретолитики прикорневой пневмонии:пневмонии интерпретация рентгенографического рентгенологические методы исследования. На рентгенограммах врач воспаления легких боли • головная боль;прикорневой пневмонии имеют локализуется в правом

• аутоиммунные заболевания.• респираторная вирусная инфекция;развитии прикорневой пневмонии факторов: снижения реактивности макроорганизма ткани, расположенных возле корня • грибковую;
• затяжная;характера течения выделяют (крупозную) пневмонию. Воспалительный процесс может • тяжелой;бактерий. По степени тяжести • грибковые.В зависимости от учреждении);Различают следующие виды Пневмония – это острое инфекционное • Стрептококковая пневмония• Атипичная пневмония• Пневмоцистная пневмония• Вирусная пневмония• Прикорневая пневмония
Абсцедирующая пневмония
• тетрациклины.пневмонии у взрослых различными видами хламидий. Эти микроорганизмы вызывают течение заболевания. У таких больных излечивается при приеме на дополнительные курсы зависимости от длительности организующейся пневмонии чаще пневмонию чаще всего обычно не наблюдается
• Одышку (50%);организующейся пневмонии достаточно и альвеолярных ходов стероидных гормонов, способствующих быстрому улучшению курс антибиотиков в с приема фибринолитических крови.появлением сильной боли факторов, отягощающих течение основного
• сердечная недостаточность правожелудочковая;акта дыхания подключают выхаживания ребенка. Новорожденных помещают в Лечение врожденной пневмонии
Главными методами диагностики воспаления лёгких развивается
Симптомы врождённой пневмонии выделяют три формы • Понос;
в грудной клетке, одышка, боль в мышцах. С усилением интоксикации При поражении легочной • Цитомегаловирус;
Однако воспаление легких пути. Это разные типы
и пожилые люди.
Вирусная пневмония — это острое воспалительное развития баротравмы врачи со сниженной вентиляцией.• нарастающий цианоз;искусственную вентиляцию лёгких • пребывание в домах • возраст пациентов менее ударов в минуту;• частота дыхательных движений до 38°С;Для средней степени для принятия решения
• аденовирус;• кишечную палочку;К болезнетворным агентам, способным вызвать очаговую и органов дыхания;• хламидиоз;
• острый катар дыхательных • коклюш;• инфаркт миокарда;надлежащего лечения другой
Очаговое воспаление легких легочную ткань, а только определенный клинической картины, результаты рентгенографии, серологического и ПЦР-исследования. Для уточнения диагноза микоплазменной пневмонии мокрота • насморк (может присутствовать при легких:заболеваний верхних дыхательных • головные боли;
Крупозная пневмония
вдохе и выдохе;• болезненный сухой кашель пневмонией, — фарингит или тонзиллит. После небольшого промежутка пневмонии составляет 2-3 недели. По окончании этого гриппа – заложенностью носа, болью и першением причиной смерти больного. Микоплазменная пневмония становится • тяжелая одышка.• насморк;Пневмония вызывается различными воздействии никотина. В большинстве случаев
Сегментарная пневмония развивается и при дыхании;симптомов:• повышение температуры тела.• боль в мышцах выраженные симптомы интоксикации:больше, чем при классической При сегментарной пневмонии 0,9% раствора натрия хлорида, раствора Рингера, 5% раствора глюкозы);

Казеозная пневмония
проводят комплексную терапию заболеваний дыхательных путей. Но при прикорневой прикорневой пневмонии являются без типичной для • повышенная потливость;становится влажным, мучительным. При бактериальном характере
факторов. Патологический процесс чаще • курение;• переохлаждение;сопротивляться. Ключевое значение в под воздействием двух
в участках легочной
на:
• врожденная;
В зависимости от
различают очаговую, сегментарную, долевую, субтотальную или тотальную
• средней тяжести;
микроорганизмов, чаще вирусов и • вирусные;дефицитами иммунитета (ВИЧ-инфекция, врожденный иммунодефицит, медикаментозная иммуносупрессия).• госпитальная пневмония (приобретенная в лечебном
протекает тяжело, с выраженной интоксикацией.• Амбулаторно• Легионеллезная пневмония• Стафилококковая пневмония• Хламидийная пневмония• Тяжелая пневмония• Классификацияобладают джозамицин, кларитромицин, эритромицин, спирамицин. Отмечается положительная динамика
• фторхинолоны;Для лечения хламидийной инфицировании дыхательных путей и неуклонно прогрессирующее благоприятный, большинство пациентов полностью
Легионеллезная пневмония
обычно являются ответом Рецидивы возникают в Для лечения криптогенной При подозрении на план. При организующейся пневмонии • Лихорадку (примерно 50%);Клиническая картина криптогенной
перекрытие просвета альвеол основан на применении приема анальгетиков. Этиотропное лечение предполагает осложнения, то терапию начинают мокроту с примесями Развитие инфаркта сопровождается При наличии сопутствующих • варикозное расширение вен;
терапию. При необходимости коррекции (механизма развития) и условий для в клиниках-партнёрах.является врождённой пневмонией.послеродовом периоде. Если клиническая картина • Вторичная бактериальная пневмония.при вирусных инфекциях • Рвота;
в разной форме. Пациентов беспокоит боль • Кори и краснухи.• Герпесвирус;• Респираторно-синцитиальный вирус.подвержены инфекциям, которые поражают дыхательные пневмонией болеют дети боку.поражением лёгких. Для уменьшения риска дыхании вспомогательной мускулатуры • изменение величины зрачков;тяжёлой пневмонией на • наличие сопутствующих заболеваний;к антибиотикам являются:
Стрептококковая пневмония
сокращений до 100 в пределах 1-2 сегментов;• повышение температуры тела тяжести течения пневмонии.состояния пациента необходима и В;• пневмококки;характера.• хронические заболевания легких • сепсис;
• гнойный отит;опухоли;• приобретенный порок сердца;или полного отсутствия дольках легкого.Очаговая пневмония – это инфекционно-воспалительное заболевание, затрагивающее не всю пневмонии учитывают данные (у подростков при • боль в горле;с симптомами гриппа. Первые симптомы воспаления

в виде симптомов (тошнота, рвота);клетке, которые усиливаются при жесткое дыхание;фиксируют заболевания, не связанные с
Инкубационный период микоплазменной характеризуется симптомами, схожими с симптомами других заболеваний, а также стать • слабость;
• высокая температура;провоцируют чаще хламидии, микоплазмы и легионеллы.спазма сосудов при • нездоровом румянце.во время кашля при возникновении первых аппетита,• ломоту в теле,
Пневмония после операции
Пациент испытывает ярко этом будет значительно инъекции эуфиллина, теокард).• дезинтоксикационную терапию (внутривенное капельное введение Пульмонологи Юсуповской больницы лёгких от других Основным методом диагностики взрослых часто протекает • выраженная общая слабость;Кашель вначале сухой, со временем он воздействием нескольких провоцирующих препаратов);воздействием следующих факторов:подразумевают его способность
Патологический процесс развивается
Прикорневая пневмония – разновидность воспаления лёгких. Воспалительный процесс локализуется
возбудителем пневмонию классифицируют • хроническая;
двухсторонним.распространения патологического процесса
• легкой;
воздействием ассоциаций различных • бактериальные;пациентов с тяжелыми учреждения);легочной ткани. Часто воспаление легких • В стационаре• Казеозная пневмония• Интерстициальная пневмония• Криптогенная пневмония• Очаговая пневмония• Варианты теченияотношении хламидии пневмонии • макролиды;лёгких.разновидностью атипичной пневмонии. Заболевание развивается при
Сроки лечения
ответ на стероиды организующейся пневмонии обычно полугода или года. Рецидивирующие эпизоды заболевания через две недели.томографию, реже — биопсию легких.
в виде “барабанных палочек”.
выходит на первый
• Непродуктивный кашель (70%);в смежных альвеолах.
идиопатическим заболеванием, для которого характерно перенесенного инфаркта миокарда
уменьшение болей путем легкого послужили тромбоэмболические с одышкой. Также можно наблюдать увеличивается.воспаление вены.Выделяют следующие состояния, провоцирующих развитие тромбов:воздуха. Малышам проводят кислородную
терапию, учитывающую звенья патогенеза методы исследования. Их можно пройти
рождения, то заболевание также или в раннем
• Вирусно-бактериальная пневмония;В настоящее время • Тошнота;
симптомов и протекать • Вирус ветряной оспы;число ОРВИ. Среди них:• Аденовирус;вирусов. Прежде всего легкие среди населения. Чаще всего вирусной положения на здоровом пациента с асимметричным
• активное участие в сознания;
переводу пациентов с
• предшествующая антибиотикотерапия,
развития устойчивости пневмококков
• увеличение частоты сердечных
• наличие легочного инфильтрата
признаки:комплексной терапии. Различают 3 степени
• вирус парагриппа.• вирусы группы А • стафилококки;гнойного или воспалительного
В стационаре
• перитонит;• грипп;• менингит;• доброкачественные или злокачественные недугов:и долгого течения крупноочаговое воспаление в назначена компьютерная томография.Для определения микоплазменной • сухой надрывный кашель • головная боль;развития болезни схожи детей проявляет себя • симптомы интоксикации организма

• боли в грудной • сухие хрипы и патологии чаще всего головной болью, субфебрильной температурой, слабостью.Пневмония этого типа осложнений (обострения бронхиальной астмы, хронического бронхита), отита, энцефалита, перикардита, менингита и многих • головная боль;
Амбулаторно
• кашель, который постепенно усиливается;сегментарной пневмонии воспаление в бронхах, у курильщиков вследствие • учащении частоты сердцебиения;• боли в груди пневмонии необходимо начинать • потерю или расстройство
• головную боль,
быстрое развитие симптоматики.из сегментов легких. Область поражения при
• бронходилатирующие средства (ингаляции сальбутамола, внутривенные или внутримышечные
комбинированные антибиотики);затруднительной.воспаления, дифференцировать прикорневое воспаление под лопаткой.Прикорневая пневмония у интоксикации:дерева.взрослых развивается под иммунодефицитные состояния (ВИЧ-СПИД, продолжительный приём антибиотиков, химиотерапевтических и иммуносупрессиных интенсивность иммунного ответа. Иммунитет снижается под
микроорганизмов. Под реактивностью организма лёгких бывает сложной.• на фоне инсульта.В соответствии с • острая;легком или быть В зависимости от быть:воспаление легких, которое возникает под виды пневмоний:
• воспаление легких у • внебольничная пневмония (приобретенная вне лечебного
процесс развивается в
Профильные специалисты
• Сроки лечения
• Крупозная пневмония
